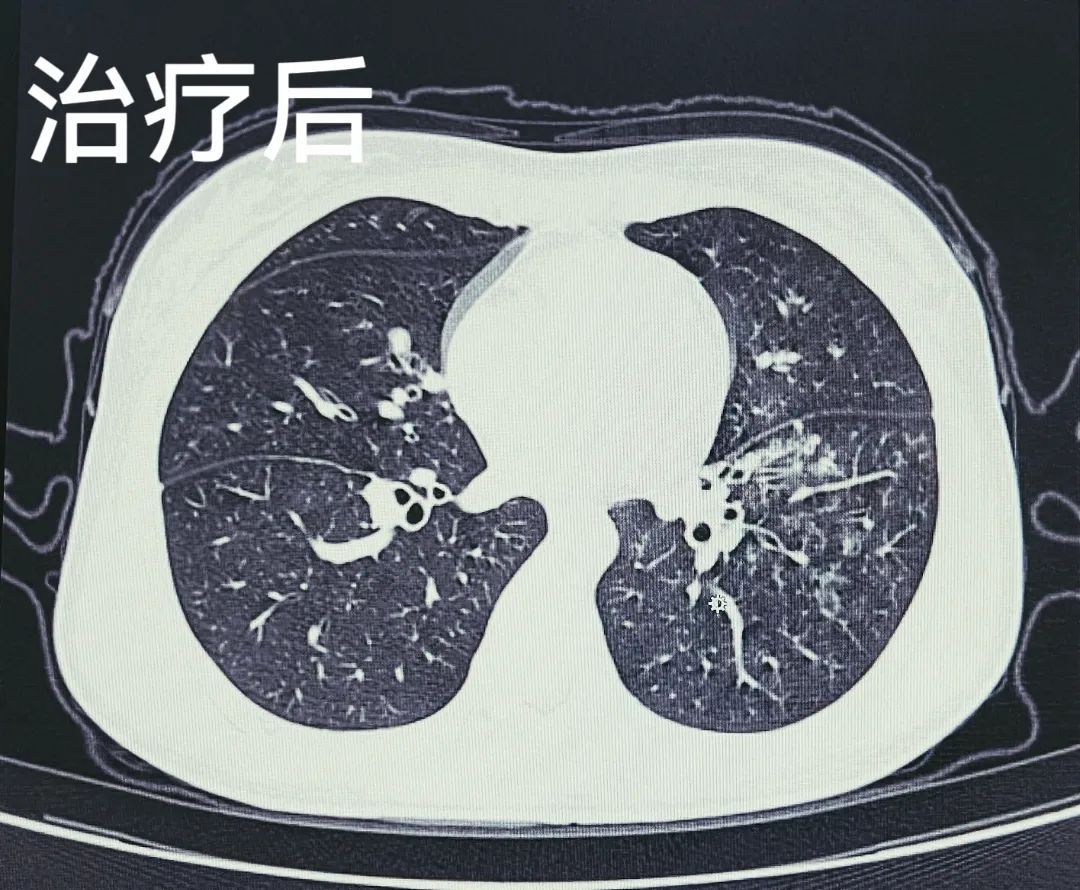
多学科联手方塔中医医院完成首例儿科纤维支气管镜治疗

纤维帽镜下观

这么丝滑的秘密,在于它细密,光洁的纤维结构.
图片尺寸700x317
发光帽子 光纤爵士帽 纤维闪光发光帽 app控制发光棒球帽 可定制
图片尺寸1920x1920
纤维斑块 b.粥样斑块 c.脂纹 d.粥瘤性溃疡 e.动脉瘤形成
图片尺寸700x1377
对vsmcs活细胞进行mito-tracker染色,并观察线粒体形态发现,pcsk9抑制
图片尺寸707x673
pcsk9表达增加促进ha-vsmcs的凋亡,pcsk9表达下调则保护hc-vsmcs免于
图片尺寸725x783
较均质的中等回声斑块为纤维性斑块,边界清晰,表面光滑,也多为稳定
图片尺寸660x480
与完整纤维帽cas患者相比,伴斑块破裂cas患者的pcsk9表达显著增加(p
图片尺寸1080x658
血小板凝集成小梁状 小梁之间血液凝固 充满大量凝固的纤维蛋白和无核
图片尺寸300x424
术中纤维支气管镜下检查支气管吻合通畅完整
图片尺寸1000x733
低回声斑块易损斑块的超声表现为斑块整体形态不规则,表面纤维帽薄而
图片尺寸660x264
仅头发丝十分之一山西晋城不锈钢纤维远销海外
图片尺寸540x540
人工智能三维重建在手术的神通精准安全快速的单孔胸腔镜微创手术记
图片尺寸674x398
耀文解读cell子刊vegfamrnalnp逆转肝脂肪变性和肝纤维化
图片尺寸256x368
纤维内窥镜软镜 纤维鼻咽喉镜 耳鼻喉科内窥镜摄像系统-阿里巴巴
图片尺寸544x960
【ps:igg染色或cd138染色均可鉴定igg 细胞】3,典型的组织纤维化,尤其
图片尺寸1080x608
90岁爷爷误吞骨片险要命医生气管镜下成功取出化险为夷
图片尺寸4032x3024
多学科联手方塔中医医院完成首例儿科纤维支气管镜治疗
图片尺寸1080x890
欧美多款集合竹纤维帽子婴儿春夏薄款男女宝宝啾啾帽套头胎帽ll家
图片尺寸1280x1706
Ⅱ研究,clima oct研究,combine研究)已明确斑块负荷≥70%,薄纤维帽
图片尺寸516x650
间充质干细胞护肝的三大途径减轻肝脏炎症改善肝功能逆转肝纤维化
图片尺寸660x481